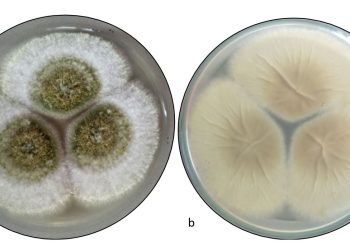

La OMS insta a adoptar políticas duras contra el alcohol para reducir los casos de cáncer
Copenhague, 15 oct (EFE).- La oficina regional europea de la Organización Mundial de la Salud (OMS) instó a los gobiernos europeos a adoptar políticas duras para reducir el consumo de ...